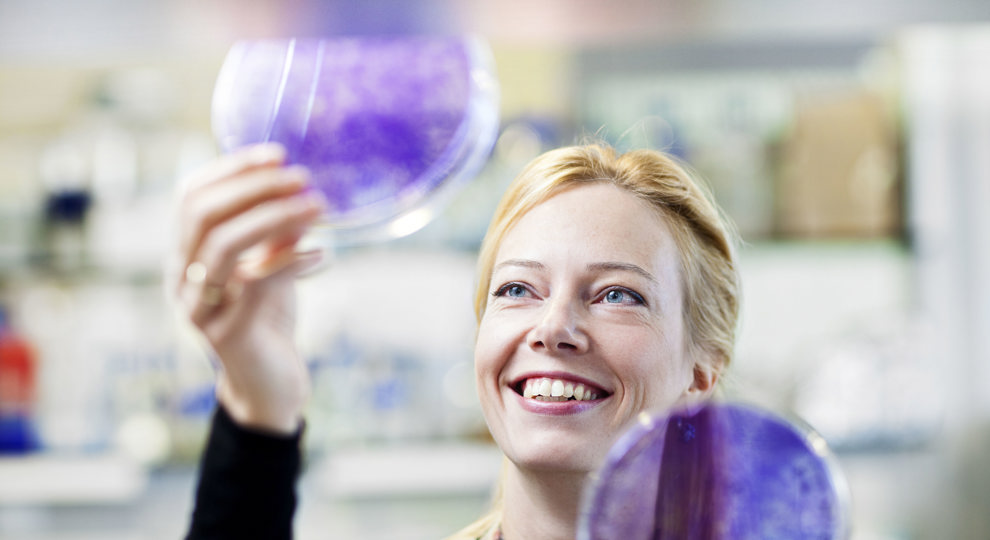
KWF steunt zes nieuwe onderzoeken | AVL

KWF steunt zes nieuwe onderzoeken.

Dankzij financiële steun van KWF Kankerbestrijding kunnen zes nieuwe onderzoeken van start. Onze wetenschappers gaan onder meer op zoek naar hoe kankercellen het immuunsysteem omzeilen en hoe ze samenwerken met elkaar en met andere cellen. Prachtig fundamenteel onderzoek dat ons helpt om kanker beter te begrijpen en behandelen.
1: Genetische afwijking:

Onder leiding van groepsleider Karin de Visser gaan wetenschappers onderzoeken hoe een veelvoorkomende genetische afwijking bij borstkanker het afweersysteem onderdrukt. Ze kijken ook hoe medicijnen die deze afwijkingen remmen, de werking van immuuntherapie kunnen verbeteren. Zo hopen ze meer gerichte behandelingen op maat te ontwikkelen.
Meer over Karin de Visser.
2: Mini-tumor:
3: Instabiel DNA:
FacesofNKI | ontmoet groepsleider Jacqueline Jacobs.
4: Bindweefselcellen:
5: Herprogrammeren:

Meer over Fred van Leeuwen.
6: Slapende kankercellen:
Leverkanker is moeilijk te behandelen door grote verschillen binnen tumoren. Onderzoeker Serena Vegna bestudeert hoe slapende kankercellen en hun interactie met afweercellen de tumor-omgeving beïnvloeden. Zo hopen onderzoekers uiteindelijk nieuwe therapieën te ontwikkelen die deze processen beter benutten.
Alpe d'HuZes maakt de projecten van Karin de Visser, Krijn Dijkstra, Fred van Leeuwen en Serena Vegna mogelijk.
